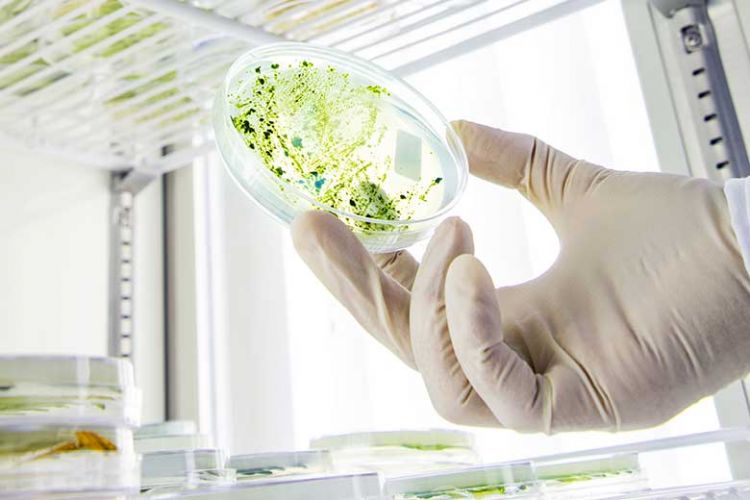
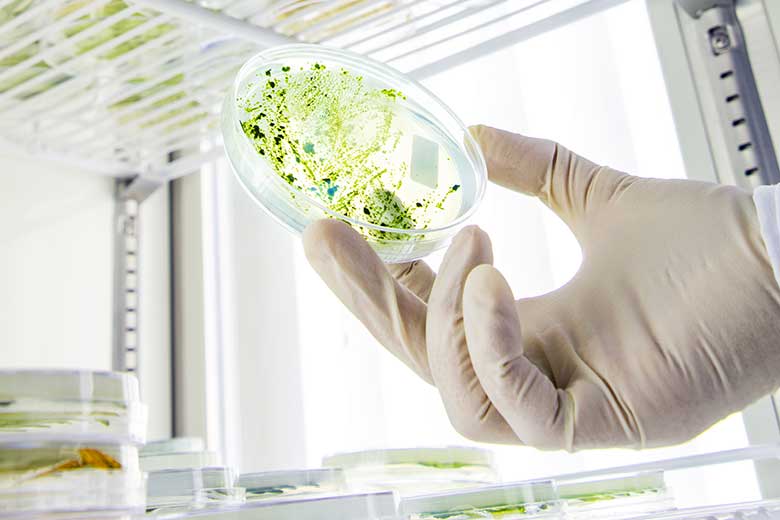
qatar_university_biofuels_hub_article

Harvesting sustainable bioresearch
The innovative cultivation of important crops has reduced the impact of food production on Qatar’s environment
It’s essential to Qatar University’s vision and mission to be a catalyst for sustainable development, helping the country to diversify away from its roots in oil and gas. Research into bioresources plays an important role in achieving that goal, whether that is by investigating alternative sources of fuel or ensuring that the population has a secure supply of food in the long term.
The university’s Centre of Sustainable Development aims to ensure that Qatar makes the most of its natural resources in a sustainable way. The centre performs research into food and water security, renewable energy, the governance of natural resources and waste management. Because of water scarcity, limited arable land and high temperatures in Qatar, securing a sustainable food production pipeline is challenging. Consequently, this is a high priority for the centre, and a new plant is currently under construction in the north of Qatar for the production of food, fuel and health products.
One of the most important research initiatives is the Algal Technologies Programme (ATP), led by Dr Hareb Mohammad Al-Jabri and his team. Qatar’s environment offers a unique biodiversity in terms of the presence of microalgae and cyanobacteria – a type of microorganism that thrives on sunlight and CO2 – and ideal year-round growing conditions due to its hot and dry climate. “We want to take advantage of the high temperatures, abundant sunlight and saline water we have here in Qatar,” explains Dr Al-Jabri. “All these conditions make cultivation of traditional crops challenging, but microalgae can thrive under our conditions, and can be a great alternative source of food and feed.”
The ATP covers five key areas of research: culture collection (comparing different algae species); biofuel (converting biomass into carbon neutral fuel); environment and bioremediation (carbon capture and wastewater treatment); health (utilisation of algae in health foods or supplements) and animal feed. Microalgae are being investigated as a source of feed for both poultry and fish (aquaculture), because researchers believe that they have the nutritional potential to provide necessary proteins, lipids and carbohydrates without requiring arable land or fresh water to grow.
In 2011, researchers at the centre began investigating different strains of algae from the local environment – their growth patterns, biochemical composition, the types of conditions in which they grew best. The ATP now houses more than 200 different algae isolates sourced from the Qatar environment in its Culture Collection for Cyanobacteria and Microalgae. Among its discoveries are “super strains” that contain higher levels of protein, fatty acids and carbohydrates, as well as secondary metabolites such as omega-3 fatty acids, beta carotene, and phycobiliproteins, which carry a higher market value. “To grow these, we need lots of sun, seawater, carbon dioxide, and any type of land,” he adds. “We can also recycle certain compounds from industry, such as urea, which is typically regarded as waste and so can’t be sold on, but can be used as a source of nitrogen.” Urea can be supplemented to algae as a fertiliser, and is necessary to support its growth.
“This type of project is good for the diversification of the economy in Qatar because it’s not dependent on oil and gas, and mitigates carbon emissions,” says Dr Al-Jabri. “We help the environment by recycling damaging chemicals, and we’re using seawater so as not to impact the scarce fresh water supply.” The department has previously looked at producing affordable and sustainable biofuels that could be used by the airline industry to reduce its carbon footprint – however this became less feasible economically because of a fall in oil prices. “Our research outcomes were good, so when this does become feasible again, we’ll be ready. But at the moment our focus is on food security for Qatar rather than fuel,” he adds.
Qatar University has been working with students and research departments in universities globally, including Murdoch University in Australia, the University of Liege in Belgium, University of Nantes in France, Wageningen University in the Netherlands, and the University of Texas in Austin. International students can visit the campus in Doha to get to know the desert environment at first hand. “Students are the main wheel of our research, they make it active,” says Dr Al-Jabri, “this is so important for knowledge exchange and to spread our networks and collaborate on different projects.”
The university has also garnered financial and research support from both the private and public sector in Qatar. The Ministry of Commerce and Industry has helped the centre fund a number of start-ups focused on algae-based products, and there are numerous corporate partnerships with companies such as Total and Qatar Airways. Total is working with the university on research into biofuel made from microalgae as well as carbon capture, utilisation and storage (CCUS). Such partnerships are not only financial sponsorships, but also explore intellectual property sharing and will help the corporations involved reach their own sustainability goals.
Another key partnership is with Japanese company Chiyoda, a specialist in agricultural and vegetable production technology. Working with Chiyoda, the university has designed and constructed a designated vegetable factory plant located on campus. The aim is to build a facility where the conditions can be controlled easily with LED lighting so that leafy crops can be produced at any time of the year. This means that the harsh desert environment in Qatar does not have to influence production, so there is continuity and consistency in how the products are grown.
The plan for the ATP is to scale up the production of microalgae and cyanobacteria as part of the university’s forward strategy. This year the cultivation will increase to two hectares of land, and by 2025 it’s hoped that production will cover as much as 100 hectares. “We have a concrete strategy to start producing this on a commercial scale, and we’re moving in the right direction,” says Dr Al-Jabri. Together with a new food production plant in the north of Qatar, this research has the potential to harness sustainable food production for years to come.
For more information, please visit www.qu.edu.qa.